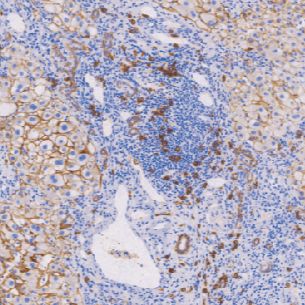
兔抗人CD138单克隆抗体 TDCCR-0781

相关产品推荐更多 >
万千商家帮你免费找货
0 人在求购买到急需产品
- 详细信息
- 文献和实验
- 技术资料
- 形态:
Liquit
- 保存条件:
-20℃
- 克隆性:
单克隆
- 适应物种:
Human,(predicted:Mouse,Rat,)
- 保质期:
1年
- 抗原来源:
peptiede
- 目录编号:
TDCCR-0781
- 级别:
科研级
- 库存:
88
- 供应商:
武汉天德
- 宿主:
兔
- 浓度:
1mg/ml
- 抗体英文名:
CD138
- 抗体名:
CD138
- 规格:
1ml工作液

CD138兔抗人CD138单克隆抗体
CD138是一种跨膜肝素硫酸蛋白,是细胞间质、质膜的重要组成成分。表达于正常淋巴细胞的不同阶段,包括浆细胞、浆母细胞和免疫母细胞。浆细胞瘤阳性表达。还表达于某些上皮细胞、血管平滑肌细胞、内皮细胞和神经细胞。头颈部鳞状细胞癌阳性预后好
- 货号:TDCCR-0781
- 克隆号:EP201
- 阳性部位:胞膜
- 适用组织:石蜡切片
- 预处理:热修复
风险提示:丁香通仅作为第三方平台,为商家信息发布提供平台空间。用户咨询产品时请注意保护个人信息及财产安全,合理判断,谨慎选购商品,商家和用户对交易行为负责。对于医疗器械类产品,请先查证核实企业经营资质和医疗器械产品注册证情况。
文献和实验抗体使用小技巧_技术资料_丁香通 (biomart.cn)
tissue,human testis tissue,human brain tissue IF:Hela,HepG2 另外有 HRP、FITC、Bintin 标记的多抗对应货号分别为: CSB-PA07179B0Rb、CSB-PA07179C0Rb、CSB-PA07179D0Rb 兔抗人淀粉样肽 beta A4 蛋白单克隆抗体 货号:CSB-MA0019501A0m 识别
一、实验原理 将抗C5a单克隆抗体包被固相聚苯乙烯板,加入经聚乙二醇(PEG)处理的待测样本,然后依次加入兔抗人C5a-IgC多克隆抗体和过氧化物酶标记的猪抗兔IsC,再加入底物2,2’-连氮-双(3-乙基苯骈唑啉-6-磺酸盐)(ABTS)和H2O2显色,于酶标仪405 mn处测定每分钟光密度增加量(OD/min),以OD/min为纵坐标,C5a标准晶浓度为横坐标绘制标准曲线图,求出待测样本中C5a的含量。 二、实验试剂 1. PBSPH7.2
蛋白质,加酶标抗抗体,保温后洗涤,加底物保温30分钟后,加酸或碱终止酶促反应,用目测或光电比色测定抗体含量。三、仪器、原料和试剂仪器聚苯乙烯96孔酶标板、微量移液管、酶联免疫阅读仪、水浴锅。原料单克隆抗体试剂1、 抗原及酶标记抗体①抗原:兔抗人IgG(Rabbit Aanti-human IgG,Code No.A0423);②酶标抗抗体:兔抗鼠IgG-HRP(Rabbit Anti-mouse IgG-HRP,Code No.P0260);均为DAKO 公司产品,使用时按照说明书要求稀释。4、 洗涤
技术资料暂无技术资料 索取技术资料